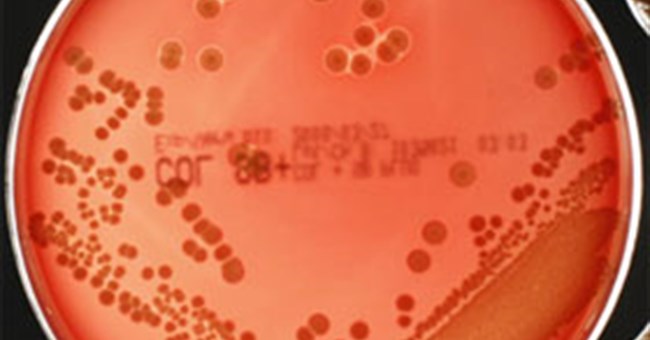
Phát hiện điểm yếu của “siêu vi khuẩn” kháng thuốc

Rhizodus hibberti: Quái vật kinh hoàng của kỷ Carbon

Rhizodus hibberti là loài cá cổ đại khổng lồ có thể thách thức trí tưởng tượng với sự hung dữ của chúng. Rhizodus hibberti: Quái vật kinh hoàng của kỷ Carbon
Tiểu hành tinh gần Trái Đất có cấu trúc xốp

Dữ liệu từ tàu vũ trụ Hayabusa2 của Nhật Bản cho thấy tiểu hành tinh Ryugu có độ xốp cao, giống như "nước cà phê đông lạnh".
Lập xuân 2020 là ngày nào?

Lập Xuân là tiết khí đầu tiên của năm, cũng là thời điểm tràn đầy mới mẻ, phấn khởi, đánh dấu sự chuyển mình rõ rệt của thời tiết và cảnh sắc. Trong 24 tiết khí, lập Xuân là tiết quan trọng hàng đầu đối với vấn đề sức khỏe, dưỡng sinh, bồi dưỡng thân thể.
Hít phải khí ozon có hại hay không?

Ozon là một dạng thù hình của oxy (loại khí duy trì sự sống), bản thân nó cũng được sử dụng để khử độc hoa quả và thực phẩm. Tuy nhiên nếu hít phải khí này sẽ tác động xấu đến sức khỏe của bạn.
Tượng đá bí ẩn khiến ta đặt ra giả thuyết : Phải chăng con người đã sống cùng thời với khủng long?

Cách đây 76 năm, 33 nghìn bức tượng đất nung được tìm thấy tại Mexico, vốn được coi là bằng chứng tiêu biểu cho giả thuyết khủng long từng chung sống cùng loài người thời tiền sử.
Tạo ra cơ thể con người… thu nhỏ trong phòng thí nghiệm

Các nhà nghiên cứu đã tạo ra những gì được cho là mô hình trong phòng thí nghiệm tinh vi nhất trên thế giới về cơ thể con người.
Gạch lego có thể tồn tại trong đại dương tới 1.300 năm

Bằng cách đo khối lượng của từng viên gạch đồ chơi LEGO được tìm thấy trên các bãi biển so với các mảnh không sử dụng tương đương, các nhà nghiên cứu ước tính rằng các vật phẩm này có thể tồn tại dưới đại dương trong khoảng từ 100 đến 1.300 năm.
Mô phỏng sao lớn gấp 1.000 lần Mặt trời phát nổ

Từ Trái Đất, chúng ta có thể quan sát vụ nổ siêu tân tinh của sao khổng lồ đỏ Betelgeuse khi nó chết vào cuối vòng đời.
Điều gì sẽ xảy ra nếu con người nhảy dù vào vòi rồng?

Nhìn từ bên ngoài, vòi rồng tựa một đám mây điên cuồng. Vận tốc gió có thể đạt 500 km/h và cuốn bay mọi thứ xung quanh. Tuy nhiên, tại khu trung tâm không khí khá mịn.
Vì sao Mỹ có nền y tế hiện đại nhưng lại thất bại trong tốc độ xét nghiệm người nghi nhiễm?

Có rất nhiều lý do khiến Mỹ rơi vào tình trạng thiếu hụt bộ kit xét nghiệm và tốc độ lấy mẫu các ca nghi nhiễm thấp hơn so với nhiều quốc gia. Trong đó không thể không nhắc đến sự chủ quan của Mỹ và cơ quan phòng dịch CDC.
Vì sao băng hình thành trên sao Thủy dù nhiệt độ lên tới 400 độ C?

Một nhóm các nhà khoa học từ Georgia Tech đã đưa ra một lời giải thích mới về cách băng hình thành trên Sao Thủy mặc dù nhiệt độ bề mặt thiêu đốt có thể đạt tới 400 độ C.
Mỹ dùng siêu máy tính mạnh nhất thế giới để tìm cách trị Covid-19

Theo ExtremeTech, Bộ năng lượng Mỹ ngày 16/2 đã thông báo sẽ sử dụng siêu máy tính Summit của IBM để tìm kiếm phương pháp điều trị Covid-19.
Vaccine (vắc xin) là gì? Tại sao vaccine không dùng để chữa bệnh mà là phòng bệnh?

Mặc dù thuật ngữ vaccine (vắc-xin) được sử dụng khá rộng rãi, ai cũng từng được tiêm vaccine nhưng vẫn có khá nhiều người hiểu lầm về vaccine, cho rằng vaccine dùng để chữa bệnh.
 Các chuyên gia tìm thấy hộp sọ khoảng 66,7-66,8 triệu năm tuổi của chim hiện đại trong mỏ đá ở Bỉ, gần biên giới với Hà Lan.
Các chuyên gia tìm thấy hộp sọ khoảng 66,7-66,8 triệu năm tuổi của chim hiện đại trong mỏ đá ở Bỉ, gần biên giới với Hà Lan. Chúng ta thường nghe nói về từ chung chung như “ gốm sứ”, vậy thế nào là gốm, thế nào là sứ và cách phân biệt chúng như thế nào?
Chúng ta thường nghe nói về từ chung chung như “ gốm sứ”, vậy thế nào là gốm, thế nào là sứ và cách phân biệt chúng như thế nào? Các lý thuyết y học của Claudius Galenus đã chi phối nền y học châu Âu hơn 1.000 năm sau khi ông qua đời, trước khi được thay thế bằng các kiến thức chính xác hơn của các nhà y học giai đoạn cuối thời Trung cổ.
Các lý thuyết y học của Claudius Galenus đã chi phối nền y học châu Âu hơn 1.000 năm sau khi ông qua đời, trước khi được thay thế bằng các kiến thức chính xác hơn của các nhà y học giai đoạn cuối thời Trung cổ. Nếu cứ tiếp tục cắm sạc khi pin đã đầy có ảnh hưởng đến tuổi thọ của pin không? Câu trả lời ở đây là các bạn có thể yên tâm rằng việc đó sẽ không gây hại gì cho pin máy cũng như toàn bộ hệ thống.
Nếu cứ tiếp tục cắm sạc khi pin đã đầy có ảnh hưởng đến tuổi thọ của pin không? Câu trả lời ở đây là các bạn có thể yên tâm rằng việc đó sẽ không gây hại gì cho pin máy cũng như toàn bộ hệ thống. Quần áo và chăn mền là thứ tiếp xúc sát nhất với cơ thể của chúng ta hàng ngày nên nếu những giọt bắn virus lây lan sang thì nguy cơ mắc bệnh vẫn có thể xảy ra.
Quần áo và chăn mền là thứ tiếp xúc sát nhất với cơ thể của chúng ta hàng ngày nên nếu những giọt bắn virus lây lan sang thì nguy cơ mắc bệnh vẫn có thể xảy ra. Việc tìm thấy xương lừa trong lăng mộ cổ giúp hé lộ vai trò của sinh vật này với cuộc sống của giới quý tộc nhà Đường.
Việc tìm thấy xương lừa trong lăng mộ cổ giúp hé lộ vai trò của sinh vật này với cuộc sống của giới quý tộc nhà Đường. Cũng như nhiều dịch bệnh khác trong quá khứ, có khả năng chúng ta sẽ đạt tới một đỉnh dịch trong Covid-19, sau đó, các trường hợp nhiễm mới bắt đầu giảm dần cho tới khi R0 giảm xuống dưới 1 và dịch bệnh sẽ bị dập tắt. Tuy nhiên, điều quan trọng chúng ta cần làm vẫn là thực hiện kết hợp mọi biện p
Cũng như nhiều dịch bệnh khác trong quá khứ, có khả năng chúng ta sẽ đạt tới một đỉnh dịch trong Covid-19, sau đó, các trường hợp nhiễm mới bắt đầu giảm dần cho tới khi R0 giảm xuống dưới 1 và dịch bệnh sẽ bị dập tắt. Tuy nhiên, điều quan trọng chúng ta cần làm vẫn là thực hiện kết hợp mọi biện p Rhizodus hibberti là loài cá cổ đại khổng lồ có thể thách thức trí tưởng tượng với sự hung dữ của chúng. Rhizodus hibberti: Quái vật kinh hoàng của kỷ Carbon
Rhizodus hibberti là loài cá cổ đại khổng lồ có thể thách thức trí tưởng tượng với sự hung dữ của chúng. Rhizodus hibberti: Quái vật kinh hoàng của kỷ Carbon Dữ liệu từ tàu vũ trụ Hayabusa2 của Nhật Bản cho thấy tiểu hành tinh Ryugu có độ xốp cao, giống như "nước cà phê đông lạnh".
Dữ liệu từ tàu vũ trụ Hayabusa2 của Nhật Bản cho thấy tiểu hành tinh Ryugu có độ xốp cao, giống như "nước cà phê đông lạnh". Lập Xuân là tiết khí đầu tiên của năm, cũng là thời điểm tràn đầy mới mẻ, phấn khởi, đánh dấu sự chuyển mình rõ rệt của thời tiết và cảnh sắc. Trong 24 tiết khí, lập Xuân là tiết quan trọng hàng đầu đối với vấn đề sức khỏe, dưỡng sinh, bồi dưỡng thân thể.
Lập Xuân là tiết khí đầu tiên của năm, cũng là thời điểm tràn đầy mới mẻ, phấn khởi, đánh dấu sự chuyển mình rõ rệt của thời tiết và cảnh sắc. Trong 24 tiết khí, lập Xuân là tiết quan trọng hàng đầu đối với vấn đề sức khỏe, dưỡng sinh, bồi dưỡng thân thể. Ozon là một dạng thù hình của oxy (loại khí duy trì sự sống), bản thân nó cũng được sử dụng để khử độc hoa quả và thực phẩm. Tuy nhiên nếu hít phải khí này sẽ tác động xấu đến sức khỏe của bạn.
Ozon là một dạng thù hình của oxy (loại khí duy trì sự sống), bản thân nó cũng được sử dụng để khử độc hoa quả và thực phẩm. Tuy nhiên nếu hít phải khí này sẽ tác động xấu đến sức khỏe của bạn. Cách đây 76 năm, 33 nghìn bức tượng đất nung được tìm thấy tại Mexico, vốn được coi là bằng chứng tiêu biểu cho giả thuyết khủng long từng chung sống cùng loài người thời tiền sử.
Cách đây 76 năm, 33 nghìn bức tượng đất nung được tìm thấy tại Mexico, vốn được coi là bằng chứng tiêu biểu cho giả thuyết khủng long từng chung sống cùng loài người thời tiền sử. Các nhà nghiên cứu đã tạo ra những gì được cho là mô hình trong phòng thí nghiệm tinh vi nhất trên thế giới về cơ thể con người.
Các nhà nghiên cứu đã tạo ra những gì được cho là mô hình trong phòng thí nghiệm tinh vi nhất trên thế giới về cơ thể con người. Bằng cách đo khối lượng của từng viên gạch đồ chơi LEGO được tìm thấy trên các bãi biển so với các mảnh không sử dụng tương đương, các nhà nghiên cứu ước tính rằng các vật phẩm này có thể tồn tại dưới đại dương trong khoảng từ 100 đến 1.300 năm.
Bằng cách đo khối lượng của từng viên gạch đồ chơi LEGO được tìm thấy trên các bãi biển so với các mảnh không sử dụng tương đương, các nhà nghiên cứu ước tính rằng các vật phẩm này có thể tồn tại dưới đại dương trong khoảng từ 100 đến 1.300 năm. Từ Trái Đất, chúng ta có thể quan sát vụ nổ siêu tân tinh của sao khổng lồ đỏ Betelgeuse khi nó chết vào cuối vòng đời.
Từ Trái Đất, chúng ta có thể quan sát vụ nổ siêu tân tinh của sao khổng lồ đỏ Betelgeuse khi nó chết vào cuối vòng đời. Nhìn từ bên ngoài, vòi rồng tựa một đám mây điên cuồng. Vận tốc gió có thể đạt 500 km/h và cuốn bay mọi thứ xung quanh. Tuy nhiên, tại khu trung tâm không khí khá mịn.
Nhìn từ bên ngoài, vòi rồng tựa một đám mây điên cuồng. Vận tốc gió có thể đạt 500 km/h và cuốn bay mọi thứ xung quanh. Tuy nhiên, tại khu trung tâm không khí khá mịn. Có rất nhiều lý do khiến Mỹ rơi vào tình trạng thiếu hụt bộ kit xét nghiệm và tốc độ lấy mẫu các ca nghi nhiễm thấp hơn so với nhiều quốc gia. Trong đó không thể không nhắc đến sự chủ quan của Mỹ và cơ quan phòng dịch CDC.
Có rất nhiều lý do khiến Mỹ rơi vào tình trạng thiếu hụt bộ kit xét nghiệm và tốc độ lấy mẫu các ca nghi nhiễm thấp hơn so với nhiều quốc gia. Trong đó không thể không nhắc đến sự chủ quan của Mỹ và cơ quan phòng dịch CDC. Một nhóm các nhà khoa học từ Georgia Tech đã đưa ra một lời giải thích mới về cách băng hình thành trên Sao Thủy mặc dù nhiệt độ bề mặt thiêu đốt có thể đạt tới 400 độ C.
Một nhóm các nhà khoa học từ Georgia Tech đã đưa ra một lời giải thích mới về cách băng hình thành trên Sao Thủy mặc dù nhiệt độ bề mặt thiêu đốt có thể đạt tới 400 độ C. Theo ExtremeTech, Bộ năng lượng Mỹ ngày 16/2 đã thông báo sẽ sử dụng siêu máy tính Summit của IBM để tìm kiếm phương pháp điều trị Covid-19.
Theo ExtremeTech, Bộ năng lượng Mỹ ngày 16/2 đã thông báo sẽ sử dụng siêu máy tính Summit của IBM để tìm kiếm phương pháp điều trị Covid-19. Mặc dù thuật ngữ vaccine (vắc-xin) được sử dụng khá rộng rãi, ai cũng từng được tiêm vaccine nhưng vẫn có khá nhiều người hiểu lầm về vaccine, cho rằng vaccine dùng để chữa bệnh.
Mặc dù thuật ngữ vaccine (vắc-xin) được sử dụng khá rộng rãi, ai cũng từng được tiêm vaccine nhưng vẫn có khá nhiều người hiểu lầm về vaccine, cho rằng vaccine dùng để chữa bệnh.